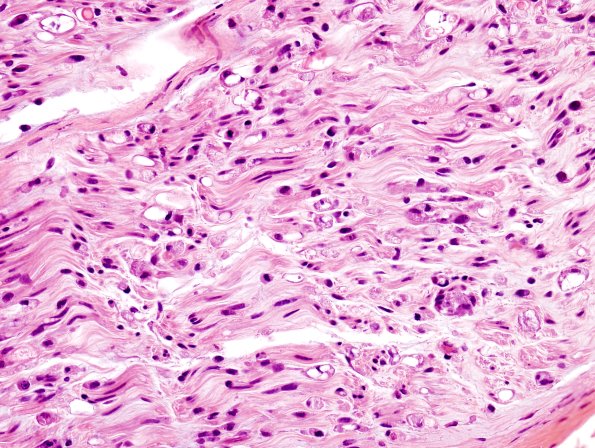
2A2 Axonal Degeneration (Case 2) H&E 4

Table of Contents
Washington University Experience | PERIPHERAL NEUROPATHY | 4 AXONAL DEGENERATION | 1 H&E & IHC | 2A2 Axonal Degeneration (Case 2) H&E 4
It is possible that there is severe vasculitis and damage proximally in this case resulting in distal degeneration of the majority of axons in the nerve, i.e., a pattern not inconsistent with mononeuritis multiplex due to vasculitis. (H&E)